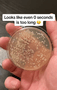

게티이미지뱅크 |
‘부동산 공법’ 분야 유명 일타강사로 알려진 남편을 살해한 혐의를 받는 아내가 결국 구속됐다.
김대현 수원지법 평택지원 영장전담 부장판사는 24일 살인 혐의로 구속영장이 청구된 50대 여성 ㄱ씨에 대한 구속 전 피의자심문을 마친 뒤 “범죄 혐의가 소명되고, 증거인멸과 도주의 우려가 있다”며 영장을 발부했다.
ㄱ씨는 지난달 15일 새벽 3시께 평택시 자신의 아파트에서 부동산 공인중개사 시험 수험생 사이에서 일타 강사로 유명한 남편 최아무개씨의 머리 부위를 양주병으로 여러 차례 때려 숨지게 한 혐의를 받는다. ㄱ씨 범행으로 머리 부위를 크게 다친 최씨는 인근 병원으로 옮겨졌으나 약 11시간만인 당일 오후 2시께 사망했다.
ㄱ씨는 범행 이후 스스로 112에 신고했다. ㄱ씨는 경찰에서 “남편이 이혼을 요구해 다투던 중에 홧김에 그랬다”는 취지로 진술한 것으로 알려졌다. 경찰과 검찰은 ㄱ씨를 상해치사 혐의로 구속영장을 청구했으나, 법원은 “증거인멸과 도주 우려가 없다”며 기각했다.
이후 경찰은 추가 조사 과정에서 사건 현장 ‘비산 혈흔’(흩어진 피) 형태가 ㄱ씨의 진술과 다르다는 점을 파악했다. 최씨의 혈흔이 신체 주변에서 집중됐는데, 크게 저항이 없이 누워 있는 상태에서 가격당했을 때 나타나는 형태로 분석됐기 때문이다. 서서 다투는 과정에서 범행이 발생했을 경우, 혈흔이 사방으로 비산해 어지럽게 흩어진 형태로 나타난다고 경찰은 설명했다. 경찰은 최씨를 살해할 고의가 있다고 판단하고, 죄명을 상해치사에서 살인 혐의로 바꿔 구속영장을 재신청했다.
이정하 기자 jungha98@hani.co.kr
▶▶한겨레는 함께 민주주의를 지키겠습니다 [한겨레후원]
▶▶실시간 뉴스, ‘한겨레 텔레그램 뉴스봇’과 함께!
▶▶한겨레 뉴스레터 모아보기